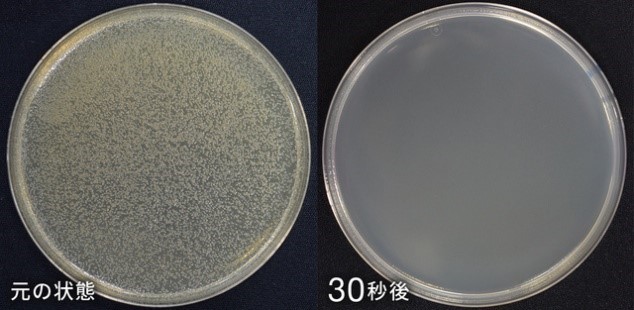
洗濯除菌剤(80mL)/1,320円(税込)

今年の夏の部屋干しに注意報発令! 部屋干し臭から衣類をまもる「洗濯除菌剤」の 一人暮らしやお試しに最適なサイズ(80mL)を7/1から販売開始
- 柔軟剤投入口に入れるだけで除菌、嫌な部屋干し臭・生乾き臭を防ぐ -
株式会社光栄産業(新潟県新潟市、代表取締役:真霜 守雄)は、一般消費者向けに展開する家庭用洗剤ブランド「DAILY CLEANERS & Co-(デイリークリーナーズ)」より、ニオイの原因菌を99.9%除菌し、「部屋干し臭から衣類をまもる洗濯除菌剤(250mL)」を販売しております。
このたび、洗濯除菌剤のシリーズとして、一人暮らしの方やお試し向けに、通常サイズよりも小さい洗濯除菌剤(80mL)を、2021年7月1日(木)から公式オンラインショップにて販売開始します。

気象庁が5月25日に発表した「3か月予報(6月~8月)」*2によると、2021年の夏は平年に比べて気温が平年並みまたは高くなるとされています。さらに、7月以降、平年に比べ曇りや雨の日が多いことが予想されます。つまり、今年の夏は「洗濯物を部屋干しする機会が増える」ことが考えられます。気温が高いと臭いのもととなる雑菌も繁殖しやすくなるため、特に今年の夏は注意が必要です。
近年、住環境などが変化し、特に都心部では部屋干しをする機会が増えています。そのため、都会に住む(一人暮らしの)若い人ほど、臭いの問題を感じることが多いといわれています。
今回発売する洗濯除菌剤(80mL)は、先行で発売している250mLに比べて小さいサイズとして、一人暮らしの方やお試しされたい方向けにお求めやすい価格で提供いたします。
クリーニングのプロによる優れた知識と技術を、家庭での洗濯で体験できる商品となっておりますので、ぜひご利用ください。
*1 全ての菌を除菌できるわけではありません。
*2 気象庁ホームページ 向こう3か月の天候の見通し6月~8月
( https://www.jma.go.jp/bosai/season/data/pdf/P3M/010000.pdf )
開発の背景
「部屋干し臭」と思っているそのニオイ、実は“衣類の洗い残し”が原因だった!
当社の洗濯に関する調査*3によると、「部屋干し臭が気になる」という回答はおよそ9割(89.4%)に上りました。
しかし実際には「部屋干し=臭い」は間違った認識で、そもそも“部屋干し臭”という臭いは存在しません。臭いの本当の原因は「きちんと衣類を洗えていないこと」です。
洗濯物に残った皮脂汚れや水分は臭いの原因菌のエサとなり、原因菌がそれらを食べて増殖、排泄するフン(糞)によって臭いが発生します。
部屋干し臭は、洗濯量を減らしたり、60℃以上のお湯につけたり、すすぎの回数を増やしたりと、汚れや衣類に合わせた洗濯を行うことで解決できますが、手間と時間がかかることも多く、日常的な洗濯に取り入れるにはハードルが高いことも少なくありません。
今回、多くの人が悩みを抱える部屋干し臭の問題を、クリーニングのプロによる優れた知識と技術を家庭での洗濯に活かすことで解決したいという思いから、本製品の開発に至りました。
*3「当社アンケート(2021年1月)」

製品の特長
- 99.9%の菌の除去(=部屋干し臭の解消)ができる洗濯除菌剤
本製品は、臭いの原因となる99.9%の原因菌を除菌します。部屋干し臭の原因菌は乾燥や紫外線にも強く、たとえ日光で乾燥させた後でもバリア状になって互いに守りあい、衣類の中に潜んでおり、着用時の汗などで活動し始め、再びニオイの原因となります。
本製品は、原因菌を徹底除菌し、臭いの原因を取り除くため、しっかりとした消臭効果を実感できます。さらに、悪臭を復活させません。この強力な除菌効果は、外部試験機関による実験で証明されました。

外部試験機関による実験の様子
2.9×10^6CFU/mlの菌が本製品に触れてから30秒で消失。
(全ての菌を除菌できるわけではありません。)
- いつもの洗濯にプラスするだけの手軽さ
いつもの洗濯時に柔軟剤と一緒に洗濯機に入れるだけで、時間や手間をかけずに手軽に強力除菌ができます。
- 衣類へのダメージなし、さらに洗濯槽も除菌できる
これまでの部屋干し臭対策では、漂白剤による除菌や60℃以上のお湯につけることが色落ちや生地のダメージの原因になったり、高温の乾燥機にかけることが衣類の型崩れや縮みを引き起こしたりと、デメリットも少なくありませんでした。本製品は、普段と同様の洗濯で衣類へのダメージを与えず部屋干し臭の解決が可能です。また、衣類と同時に洗濯槽のカビへの除菌効果も認められています。
製品概要
品名 :洗濯用除菌剤
価格 :1,320円(税込) ※別途送料が発生いたします。
用途 :綿・麻・毛・絹・合成繊維用
成分 :カチオン系界面活性剤、グリコール類、水
正味量 :80mL (1回の洗濯に約5mL)
原産国 :日本
使用方法:洗濯機の柔軟剤投入口に本品をいれて洗濯する。
柔軟剤との併用または単品での利用が可能。(洗濯洗剤は別途使用)
■プロの技術で開発、家庭用洗濯洗剤「DAILY CLEANERS & Co-(デイリークリーナーズ)」
長年にわたりクリーニング業界のプロ用洗剤を提供してきた洗濯のプロである光栄産業が一般消費者向けに立ち上げたブランドです。大切な衣類を家庭で洗濯し、長く愛用し続けるための商品を数多く展開しています。
長年アパレル業界で働いてきたデイリークリーナーズ代表の真霜は、「クリーニング不要」を謳うファッションの台頭で時代の主流は家庭洗剤と確信していました。その一方で、クリーニング業界が培ってきた技術や知識の豊富と家庭洗濯との明らかな質の違いを目の当たりにします。それがブランド誕生のきっかけになりました。
「手軽で使いやすい洗剤はもちろん重宝するし、便利。でも、本当に大事にしたい衣類には、きちんと適した洗剤を使い、正しい洗い方をしてあげたい。プロの技術を使えば、家庭洗濯でもそれが叶えられる―。」
そんな想いから誕生したのが、クリーニングの技術と知識が詰まった一般家庭向けの洗剤、「DAILY CLEANERS & Co-(デイリークリーナーズ)」です。
これまでにも、Makuakeにて2種類の洗濯用洗剤を開発・販売するプロジェクトを成功させており、多くの方々にご好評をいただいております。
公式オンラインショップURL
光栄産業について
会社名 :株式会社光栄産業
代表者 :代表取締役:真霜 守雄
所在地 :新潟県新潟市北区木崎 1811-6
事業内容:クリーニング資材の販売、クリーニング機械の販売及びメンテナンス、
工業用品販売、ウエスの販売及びレンタル、
コインランドリー機械・消耗品の販売及びサポート
コーポレートサイトURL